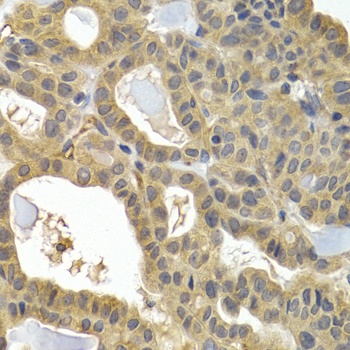
HSPB8 Antibody

You have no items in your shopping cart.
HSP22 Antibody
Description
Research Area
Images & Validation
−| Tested Applications | ICC, IF, IHC, IP, WB |
|---|---|
| Dilution range | WB (1:1000), ICC/IF (1:100), IHC (1:100); optimal dilutions for assays should be determined by the user. |
| Reactivity | Human, Mouse, Rat |
| Application Notes |
Key Properties
−| Host | Rabbit |
|---|---|
| Clonality | Polyclonal |
| Immunogen | Human HSP22 |
| Target | HSP22 |
| Molecular Weight | 22kDa |
| Purification | Peptide Affinity Purified |
| Conjugation | Unconjugated |
Storage & Handling
−| Storage | Maintain refrigerated at 2-8°C for up to 2 weeks. For long term storage store at -20°C in small aliquots to prevent freeze-thaw cycles. |
|---|---|
| Buffer/Preservatives | PBS pH 7.4, 50% glycerol, 0.09% sodium azide *Storage buffer changes when conjugated |
| Concentration | 1 mg/ml |
| Disclaimer | For research use only |
Alternative Names
−Similar Products
−HSPB8/Hsp22 Antibody [orb18992]
FC, ICC, IF, IHC, IP, WB
Human, Mouse, Rat
Rabbit
Polyclonal
Unconjugated
100 μgSigma1-receptor/SIGMAR1 Antibody [orb1097966]
ELISA, IHC, WB
Human, Monkey, Mouse, Rat
Rabbit
Polyclonal
Unconjugated
100 μgMouse Heat Shock Protein Beta 8 (HSPb8) ELISA Kit [orb780242]
Mouse
0.16-10 ng/mL
0.059 ng/mL
96 T, 48 T

Quality Guarantee
Explore bioreagents carefree to elevate your research. All our products are rigorously tested for performance. If a product does not perform as described on its datasheet, our scientific support team will provide expert troubleshooting, a prompt replacement, or a refund. For full details, please see our Terms & Conditions and Buying Guide. Contact us at support@biorbyt.com.

Immunocytochemistry/Immunofluorescence analysis using Rabbit Anti-HSP22 Polyclonal Antibody. Tissue: HaCaT cells. Species: Human. Fixation: Cold 100% methanol at -20C for 10 minutes. Primary Antibody: Rabbit Anti-HSP22 Polyclonal Antibody at 1:100 for 12 hours at 4°C. Secondary Antibody: FITC Goat Anti-Rabbit at 1:50 for 1-2 hours at RT in dark. Localization: Nuclear Staining.

Western blot analysis of Rat Skeletal muscle lysates showing detection of HSP22 protein using Rabbit Anti-HSP22 Polyclonal Antibody. Load: 15 μgprotein. Block: 1.5% BSA for 30 minutes at RT. Primary Antibody: Rabbit Anti-HSP22 Polyclonal Antibody at 1:1000 for 2 hours at RT. Secondary Antibody: Donkey Anti-Rabbit IgG: HRP for 1 hour at RT.

Immunohistochemistry analysis using Rabbit Anti-HSP22 Polyclonal Antibody. Tissue: backskin. Species: Mouse. Fixation: Bouin's Fixative Solution. Primary Antibody: Rabbit Anti-HSP22 Polyclonal Antibody at 1:100 for 1 hour at RT. Secondary Antibody: FITC Goat Anti-Rabbit (green) at 1:50 for 1 hour at RT. Localization: Epidermis positive, dermal staining.

Immunohistochemistry analysis using Rabbit Anti-HSP22 Polyclonal Antibody. Tissue: Spinal cord. Species: Mouse. Primary Antibody: Rabbit Anti-HSP22 Polyclonal Antibody at 1:100. Secondary Antibody: Alexa Fluor 488 Goat Anti-Rabbit. DAPI merged with Alexa 488.
Quick Database Links
UniProt Details
−NCBI Gene Details
−NCBI Reference Sequences
−| Protein | NP_055180.1 |
|---|
Documents Download
Request a Document
Protocol Information
HSP22 Antibody (orb1822421)
Participating in our Biorbyt product reviews program enables you to support fellow scientists by sharing your firsthand experience with our products.
Login to Submit a Review